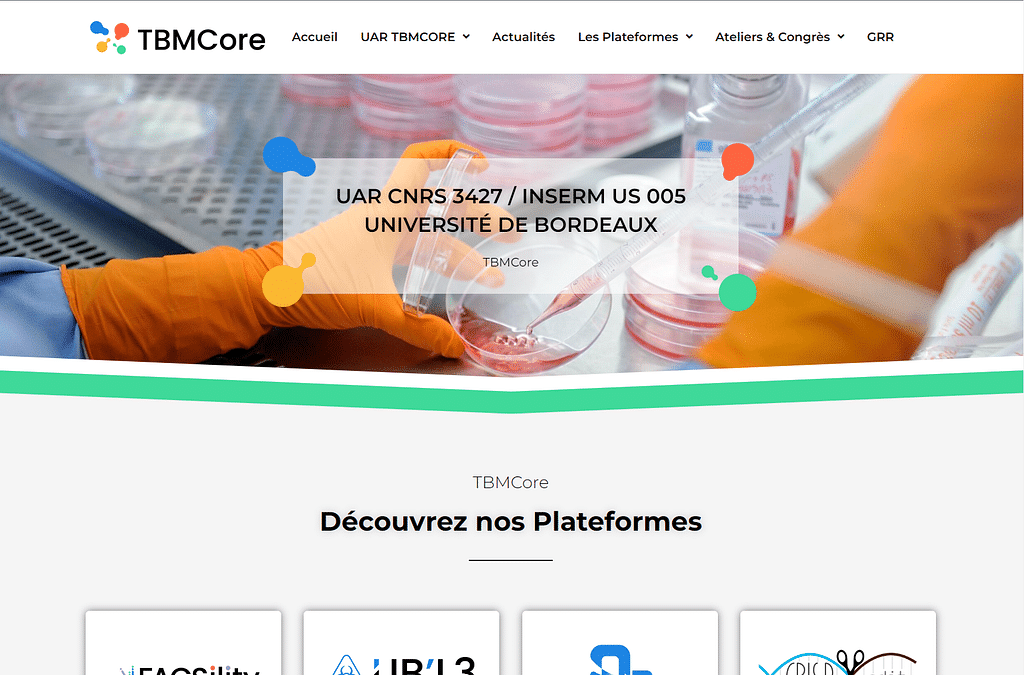
TEMP_PROFILEIc

Nivo-Web Overview
Nivo-Web is a cutting-edge digital marketing agency based in the beautiful city of Bordeaux, France. Established in 2019, our team of talented professionals is dedicated to providing top-notch service... Read More
Services
22 services offered by Nivo-WebReviews
10 reviews for Nivo-WebNous souhaitions créer un site évolutif présentant notre gamme de produit. Nous étions à la recherche d'un partenaire durable. La disponibilité de Victor est particulièrement agréable, il suit notre dossier avec soin, je peux l'appeler chaque jour par période et il se rend disponible en fonction de la demande. Il propose toujours des solutions techniques à des problématiques peu commune. Un expert.
Création de mon site web en intégrant un système de formation en ligne Les solutions proposées, l'écoute et l'accompagnement : on sent que Nivo-Web maitrise sont sujet.
Maintenance et amélioration de notre site web La souplesse et les solutions proposées, ainsi que la compréhension de mon travail
L’objectif était de refaire le visuel du site marchand pour qu’il corresponde plus à l’univers de notre marque. La disponibilité de Victor, son écoute, son travail et ses conseils qui ont été précieux.
Modifications d’un site vitrine déjà existant Agence très sérieuse, professionnelle, à l’écoute et réactive
Réalisation d’un outil de promotion pour notre groupe musical Interlocuteur sympathique et très pro, réactivité suite à notre demande
L’objectif était de m’aider à faire de la programmation en langage C J’ai apprécié le professionnalisme et l’efficacité.
L'installation d'un second système d'exploitation sur mon ordinateur La fluidité et la clarté de l'échange, je n'ai eu aucun mal à réaliser ce que je voulais
Réaliser une vidéo d’introduction pour un événement en ligne. La rapidité et la compréhension de mes attentes.
Je souhaitais avoir un site web efficace qui reflète mon activité la réactivité, le travail qualitatif et rapide de nivo-web
Portfolio
10 projects performed by Nivo-Web
The project "Création du site de TBMCore" aims to develop a website for TBMCore, a technology company specializing in blockchain solutions. The website will serve as a platform to showcase the company's products, services, and expertise in the field of blockchain technology.

The Refonte du site les-soeurs-granger.fr project aims to redesign and revamp the existing website for Les Soeurs Granger, a boutique specializing in handmade jewelry and accessories.

Page Joint Congress 2023 pour Evolis is a prestigious event that brings together industry experts, thought leaders, and stakeholders in the field of page joint technology. This Congress serves as a platform for knowledge sharing, networking, and collaboration in the evolving landscape of page joint technologies.

Création du site lbeautyskin.fr is a project aimed at creating an online platform for a beauty skincare brand. The website will showcase the products, provide information about the brand, and offer a seamless shopping experience for customers.

La Bulles sur Rouvres is a community project aimed at promoting sustainability and green living in the town of Rouvres. The project focuses on creating a network of bubble domes that serve as eco-friendly accommodations for visitors and residents alike.

Boucherie Tocqueville is a project dedicated to promoting sustainable and ethical practices in the meat industry. Our goal is to provide consumers with high-quality, locally sourced meat products while also supporting small-scale farmers and reducing the environmental impact of meat production.

Le Labo Basque is a project aimed at promoting and preserving the unique cultural heritage of the Basque region in France and Spain. Through various initiatives and collaborations, the project seeks to highlight the traditional crafts, cuisine, and language of the Basque people.

Riviera Ristorante is a charming Italian restaurant located in the heart of the city, known for its authentic cuisine and warm ambiance. With a focus on using fresh, high-quality ingredients, our menu offers a variety of traditional Italian dishes and delicious wines.

Feba Construction is a leading construction company specializing in high-quality residential and commercial projects. Their new website aims to showcase their portfolio and services to potential clients.

The project Jean-Michel Guenichot is a unique initiative aimed at revolutionizing the way businesses approach sustainability and corporate responsibility.

